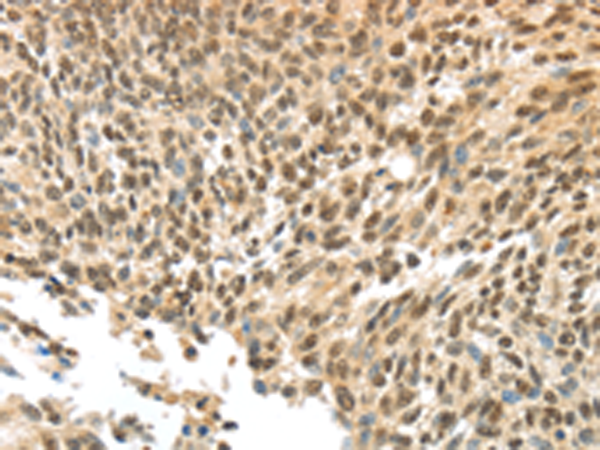
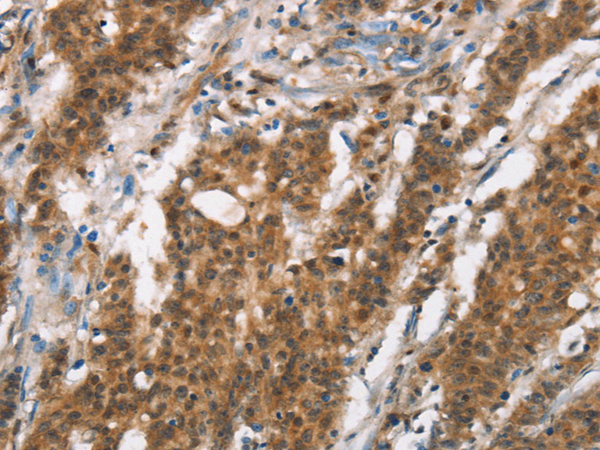
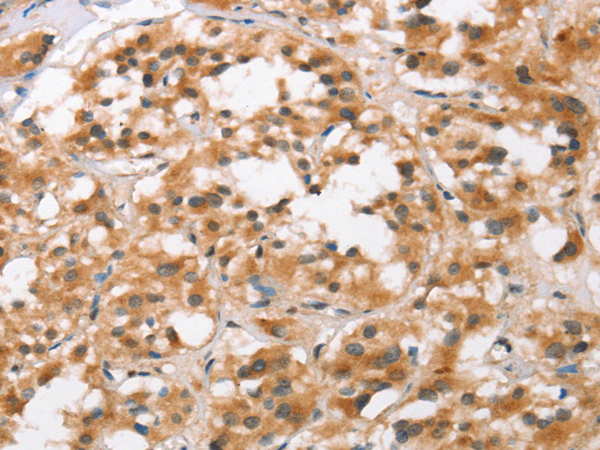

-
分类: 科研抗体货号: P11552别名: 5-HT3B应用: IHC反应种属: Human
-
分类: 科研抗体货号: P11573别名: HYDM; PAN7; NALP7; NOD12; PYPAF3; CLR19.4应用: IHC反应种属: Human
-
分类: 科研抗体货号: P11582别名: ARFL3应用: WB反应种属: Human, Mouse, Rat
-
分类: 科研抗体货号: P11572别名: PD1; NACP; PARK1; PARK4应用: IHC反应种属: Human, Mouse, Rat
-
分类: 科研抗体货号: P11581别名: APS应用: IHC反应种属: Human, Rat
-
分类: 科研抗体货号: P11571别名: PPH2; MADH6; MADH9; SMAD8; SMAD8A; SMAD8B应用: WB,IHC反应种属: Human, Mouse
-
分类: 科研抗体货号: P11580别名: APOLVI; APOL-VI应用: IHC反应种属: Human
-
分类: 科研抗体货号: P11569别名: VA; COX; COX-VA应用: WB,IHC反应种属: Human, Mouse, Rat
-
分类: 科研抗体货号: P11579别名: ADNP1应用: IHC反应种属: Human, Mouse, Rat
-
分类: 科研抗体货号: P11597别名: CNOL应用: WB,IHC反应种属: Human

鄂公网安备42018502007531号
鄂公网安备42018502007531号

